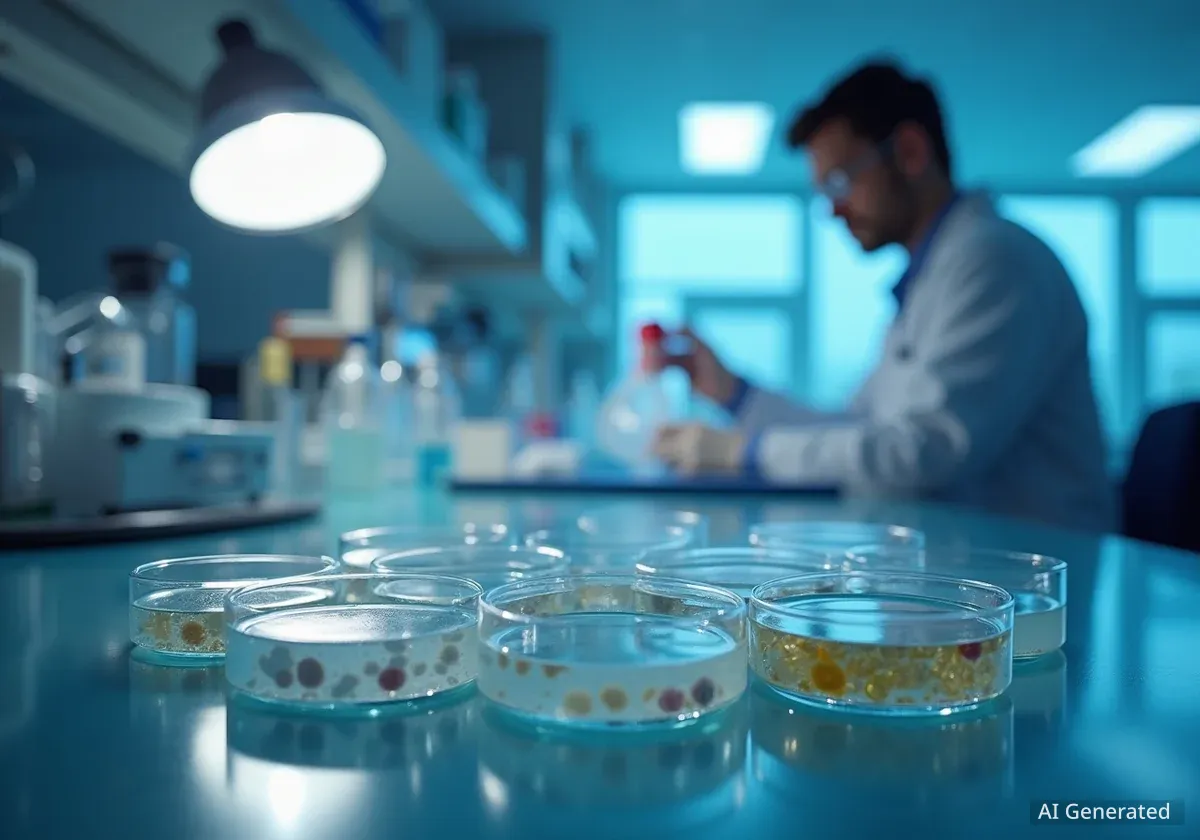
Vacuna contra herpes zóster reduce riesgo de demencia

Mujer de 46 años diagnosticada con Alzheimer precoz
Staci Marklin, de 46 años, fue diagnosticada con Alzheimer de aparición temprana. Lo que comenzó como olvidos y confusión atribuidos al posparto, se intensificó afectando su vida laboral y familiar. S
#Alzheimer#Demencia#Salud